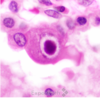
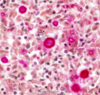

Pictures Flashcards
(80 cards)

eiosinophils from nasal smear of allergic rhinitis

nasal polyps

nasal polyp histology

- allergic mucin -sloughed epitheial cells, esionophils, charcot layden crystals, fungal hyphae
- allergic fungal sinusitis

frontal sinus mucocele (empyema) secondary to sinusitis

mucomycosis

mucorycosis

asteroid body & shaumann bodies
sarcoidosis

non necrotizing epitheloid granulomas
sarcoidosis

accumulation of macrophages in alveolar spaces
desquamative interstitial pneumonia

stellate shaped nodule formed by collections of langerhans cells near bronchioles
langerhans cell histiocytosis

- langerhans cell histiocytes
- arrows pointing to nuclear gooves

birbeck granules in langerhans cells (seen on EM)
langerhans cell histiocytosis



complicated CWP

simple CWP

silicosis




asbestos bodies

pleural plaques
asbestos

nasopharyngeal angiofibroma (staghorn antlers)

schneiderian papilloma

schneiderian papilloma, endophytic type

olfactory neuoroblastoma
(blue cells)